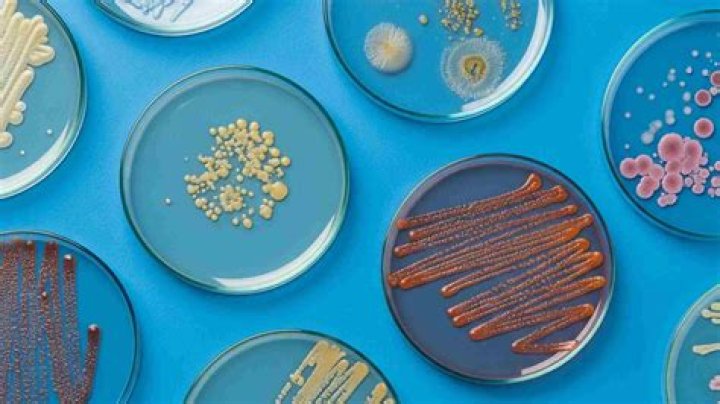

Is a boba shop profitable?

Sarah Cherry
Updated on April 21, 2026
In this regard, how much does it cost to make boba?
On average, a store charges $3.00-$3.50 USD for a serving of bubble tea (16oz or 20oz serving). However, the approximate cost for materials approximately $0.75 USD to make. That's about a 350% markup.
Likewise, does Starbucks have boba? Starbucks does not have Boba. Although they may add it to the menu at some point, at the current time, you are not going to find this option at your local store. However, some people have found ways to order drinks that taste very similar to Boba tea or Bubble tea.
Beside this, is Boba a waste of money?
Even on an ecological level, Bubble Tea is poisonous because of the plastic it generates. And finally, many people buy bubble tea because it is an inexpensive treat. Nevertheless, it's still a waste of money. Don't fall for the cheap price listed, it's an unnecessary luxury in the first place.
Why is Boba so expensive?
The final reason is that bubble tea is, undoubtedly, famous and trendy. Just about any food or drink that has become a trend or famous the way that bubble tea has is going to have a marked-up price so that companies and businesses can make more money from the tea than they otherwise would be able to.
Related Question Answers
Is Boba good or bad for you?
Unfortunately, boba itself provides very few health benefits, though its calories and carbohydrates can provide you with a boost in energy. In most cases, boba tea contains high levels of sugar, which is linked to long-term health conditions like diabetes and obesity.How profitable is bubble tea business?
How much profit can a bubble tea business make? A 350 percent markup on a beverage is not unreasonable. Gross profit margins in the 75-80 percent range are not rare in the food and beverage retail industry.What does Boba taste like?
What Does Boba Taste Like? Mostly, very sweet! Usually frothy yet creamy with the texture of tapioca balls when slurped through a straw. Not quite as icy cold or as thick as a milkshake or juice bar drink, unless it's a slushy version.How do I start a Boba business?
Here are some helpful steps to follow for starting your own bubble tea business.- Define the Concept of Your Store.
- Create and Understand Your Brand.
- Pick a Good Store Location.
- Write a Business Plan.
- Design Your Store.
- Use Technology and Tracking Applications.
- Hire and Train Employees.
- Obtain Appropriate Permits and Licenses.